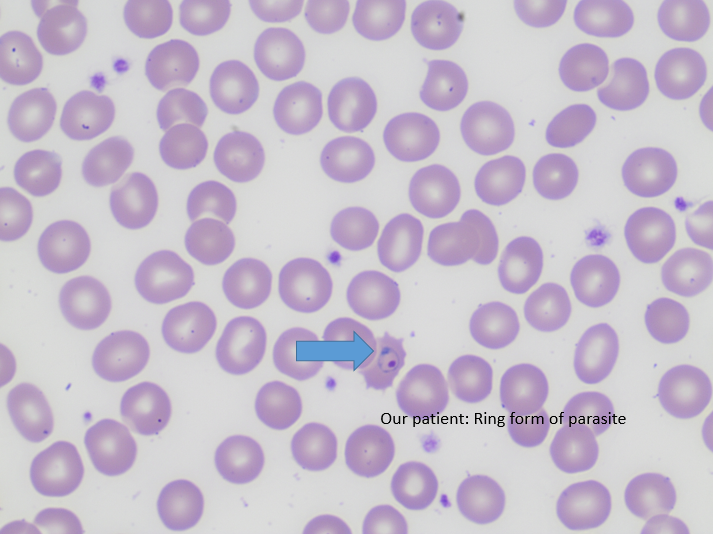
mal2

Case History
The infectious disease service was consulted on an 81 year old female for persistent fevers. She initially presented a few weeks prior with cough & shortness of breath which was diagnosed as an acute chronic obstructive pulmonary disease (COPD) exacerbation for which she received levofloxacin and steroids. The patient continued to have a persistent cough and dysphagia after discharge. Her respiratory status and cough worsened and she was readmitted and intubated. Vancomycin, piperacillin/tazobactam and levofloxacin were started as well as fluconazole for suspected esophageal candidiasis. Her past medical history was significant for breast cancer, atrial fibrillation, and diabetes mellitus. Of note, patient was originally from Puerto Rico but moved to the United States 40 years ago and denied recent travel and any known tuberculosis exposures. She formerly worked in a deli packing cheeses. A bronchoscopy was performed and a brochoalveolar lavage (BAL) specimen as well as blood and stool specimens were submitted for bacterial culture and ova and parasite exam.
Laboratory Identification


The bronchoscopy revealed a bloody fluid admixed with clots which was clinically consistent with diffuse alveolar hemorrhage. The roundworms depicted above were identified in both the BAL and stool O&P exam. Based on the presence of the short buccal cavity and the prominent genital primordium and the absence of eggs, the identification of Strongyloides stercoralis was made. Given the large amount of larvae present in both the lungs and gastrointestinal tract, the patient was diagnosed with a strongyloidiasis hyperinfection.
Discussion
Strongyloides stercoralis is classified as a nematode (roundworm) and is the cause of strongyloidiasis in humans. The helminth is found worldwide, especially in warm climates and underdeveloped countries, and is the cause of 30-100 million infections. Infection is due to fecal contamination of soil, where free-living forms are found, or water. Infective filariform larvae penetrate intact skin, particularly bare feet, resulting in infection. The free living cycle begins with the rhabditiform larvae passed through the stool develops into the infective filariform larvae or when the rhabditiform larvae mature into free living adult male & female forms that mate and produce eggs which then hatch and become infective filariform larvae that can infect humans. The parasitic life cycle begins with the infective filariform larvae penetrates human skin. The worm is then either coughed up from the lungs and swallowed or migrates to the small intestine where eggs are laid and hatch.
Patients may present with gastrointestinal symptoms such as abdominal pain, bloating, and diarrhea, pulmonary symptoms like dry cough and throat irritation, or skin rashes along points of entry (feet, ankles). When the larvae are in the lung, Loeffler’s syndrome, characterized by pneumonia symptoms with coughing and wheezing, may develop due to an accumulation of eosinophils in response to the parasitic infection. In patients who are immunocompromised, the rhabditiform larvae can develop into the filariform larvae in the host and can directly penetrate the bowel mucosa or perianal skin resulting in autoinfection, dissemination throughout the body, and high parasite burden. Symptoms of hyperinfection include bloody diarrhea, bowel perforation, destruction of lung parenchyma with bloody sputum, meningitis, and septicemia. Hyperinfection most commonly occurs after steroid administration for asthma or COPD exacerbation, but can also be seen in those receiving chemotherapy or who have had organ transplants.
In the laboratory, the diagnosis of S. stercoralis is most often made by an ova and parasite exam of the stool, duodenal fluid, sputum or BAL specimens (Image 1). Most commonly the rhabditiform larvae are present and are identified by the presence of a short buccal cavity and prominent genital primordium (Image 2). These two features are helpful in distinguishing S. stercoralis from hookworms (Ancylostoma spp. and Necator americanus) which have a longer buccal cavity and indistinct genital primordium. The eggs of these two nematodes are also very similar, although typically S. stercoralis eggs hatch before they are passed in stool specimens. S. stercoralis can also be visualized on H&E histology sections in the crypts of intestinal biopsies where the adult female measures up to 2.2 mm in length. Finally, serologic testing can be helpful when there is a high suspicion of disease in the face of multiple negative stool exams, but cannot distinguish between a current or past infection. Most patients do not remember a specific exposure and prevention includes wearing gloves and shoes when handling or walking on soil that may contain contaminated fecal material. Treatment options for an acute or chronic S. stercoralis include a short course of ivermectin or albendazole. In the case of disseminated infection, ivermectin should be given until stool and sputum exams are negative for 2 weeks. In the case of our patient, she was started on ivermectin, but succumbed to the disease due to extensive pulmonary hemorrhage.

-Jaswinder Kaur, MD, is a fourth year Anatomic and Clinical Pathology resident at the University of Mississippi Medical Center.

-Lisa Stempak, MD, is an Assistant Professor of Pathology at the University of Mississippi Medical Center in Jackson, MS. She is certified by the American Board of Pathology in Anatomic and Clinical Pathology as well as Medical Microbiology. She is the Director of Clinical Pathology as well as the Microbiology and Serology Laboratories. Her interests include infectious disease histology, process and quality improvement, and resident education.